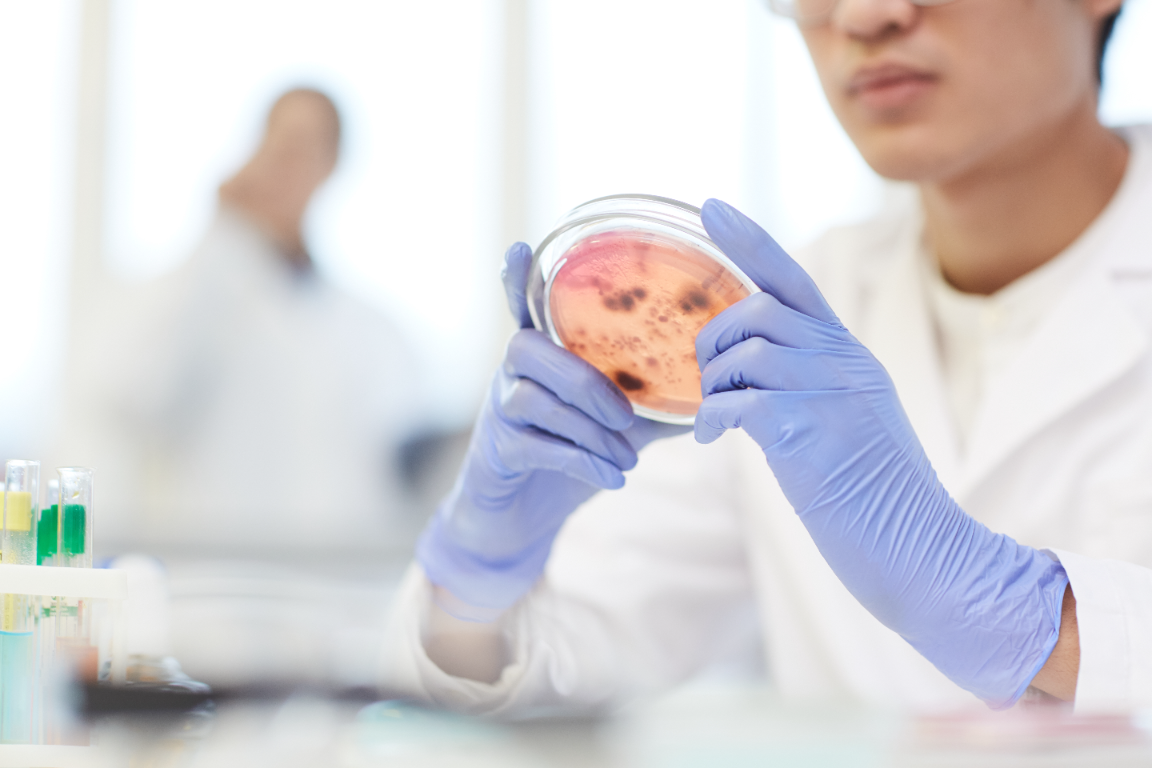
Dr Atasoy Kliniği

Kök Hücre Tedavileri
Kök hücre tedavileri, modern tıbbın en ileri düzey yenilenme ve onarım yöntemlerinden biridir. Vücudun kendi kendini iyileştirme potansiyelini kullanarak dokuları, organları ve cilt hücrelerini yeniden yapılandırmayı hedefler.
Dr. Atasoy Kliniği, kök hücre tedavisini yalnızca estetik bir uygulama olarak değil, yaşlanmayı yavaşlatan, bağışıklığı güçlendiren ve vücudu hücresel düzeyde yenileyen bir bilimsel yaklaşım olarak uygular.
Bu yöntem sayesinde yaşlanma süreci yavaşlatılır, hasar görmüş hücreler yenilenir ve vücudun biyolojik saati geriye alınır.
Kök Hücre Nedir?
Kök hücreler, vücuttaki tüm hücre türlerine dönüşme kapasitesine sahip “ana hücrelerdir”.
Yani kas, sinir, damar, kemik, cilt veya yağ hücresine dönüşebilme yetenekleri vardır.
Bu özellikleri sayesinde, hasar görmüş veya yaşlanan dokuların yenilenmesinde büyük rol oynarlar.
Dr. Atasoy Kliniği’nde kullanılan kök hücreler genellikle otolog (kişinin kendi dokusundan elde edilen) hücrelerdir.
Bu yöntem tamamen doğal, güvenli ve alerji riski taşımayan bir tedavi şeklidir.
Kök Hücre Tedavisi Nasıl Çalışır?
Kök hücreler uygulandıkları bölgedeki zayıf, hasarlı veya yaşlanmış hücreleri tespit eder ve onların yerine geçer.
Aynı zamanda çevre dokulara büyüme faktörleri ve yenilenme sinyalleri göndererek hücresel onarım sürecini başlatır.
Bu süreçte dokular kendini onarır, kan dolaşımı artar ve bağ dokusu güçlenir.
Kısacası kök hücre tedavisi, vücudun kendi yenilenme potansiyelini aktive eden biyolojik bir yeniden yapılanma yöntemidir.
Dr. Atasoy Kliniği’nde Kullanılan Kök Hücre Türleri
1. Yağ Dokusu Kaynaklı Kök Hücre (Adipoz Türevli)
En yaygın kullanılan kök hücre kaynağıdır.
Hastanın karın veya uyluk bölgesinden minimal liposuction yöntemiyle alınan az miktarda yağ dokusundan kök hücreler izole edilir.
Bu hücreler yüksek oranda mezenkimal kök hücre içerir ve doku yenilenmesinde son derece etkilidir.
Uygulama sonrası cilt gençleşir, elastikiyet artar ve yara izleri azalır.
Ayrıca eklem, kas ve sinir dokularında da onarıcı etki sağlar.
2. Kemik İliği Kaynaklı Kök Hücre
Kemik iliği, doğal kök hücre açısından zengindir.
Bu yöntem, özellikle dejeneratif hastalıklar, eklem kıkırdak problemleri ve kas iskelet sistemi hasarlarında tercih edilir.
Kemik iliğinden alınan hücreler laboratuvar ortamında yoğunlaştırılır ve tedavi bölgesine uygulanır.
Hücrelerin farklı dokulara dönüşme potansiyeli oldukça yüksektir.
3. PRP Destekli Kök Hücre Uygulamaları
PRP (Platelet Rich Plasma), kişinin kendi kanından elde edilen büyüme faktörleriyle zenginleştirilmiş plazmadır.
Kök hücrelerle birlikte kullanıldığında rejeneratif (yenileyici) etki katlanarak artar.
Cilt gençleştirme, saç dökülmesi ve vajinal yenileme gibi estetik uygulamalarda bu kombinasyon sıklıkla tercih edilir.
4. Fibroblast ve Ekzom Bazlı Hücre Tedavileri
Fibroblastlar, kolajen üretiminden sorumlu ana hücrelerdir.
Kişinin kendi derisinden alınan örneklerle laboratuvar ortamında fibroblast üretimi sağlanır ve yeniden cilde enjekte edilir.
Bu yöntem özellikle ince kırışıklıklar, cilt sarkması ve yara izleri için etkilidir.
Ekzom bazlı tedaviler ise hücreler arası iletişimi artırarak gençleşmeyi hücresel seviyede tetikler.
Kök Hücre Tedavisinin Kullanım Alanları
Dr. Atasoy Kliniği’nde kök hücre tedavileri, yalnızca estetik amaçlı değil; aynı zamanda fonksiyonel tıp uygulamalarının bir parçası olarak da kullanılır.
Kullanım alanları şunlardır:
-
Cilt gençleştirme ve sıkılaştırma
-
Yara ve akne izlerinin giderilmesi
-
Saç dökülmesi tedavisi
-
Eklemlerde kıkırdak onarımı (diz, kalça, omuz)
-
Romatizmal eklem rahatsızlıkları
-
Vajinal yenileme ve kozmetik jinekoloji uygulamaları
-
Yüz, boyun ve el bölgesi rejuvenasyonu
-
Kas ve tendon hasarlarında iyileşme
-
Anti-aging protokolleri (biyolojik yaşın yavaşlatılması)
Bu uygulamalar, vücudun doğal rejenerasyon kapasitesini artırarak uzun süreli sonuçlar sağlar.
Cilt Gençleştirmede Kök Hücre Uygulaması
Cilt, yaşlanmayla birlikte kolajen üretimini ve yenilenme hızını kaybeder.
Kök hücre tedavisiyle cilde enjekte edilen mezenkimal hücreler, fibroblast aktivasyonunu artırır ve kolajen sentezini yeniden başlatır.
Birkaç hafta içinde ciltte:
-
Parlaklık,
-
Elastikiyet artışı,
-
Gözenek küçülmesi,
-
Renk tonunda eşitlik,
-
İnce kırışıklıklarda azalma gözlenir.
Bu sonuçlar 6–12 ay boyunca devam eder, düzenli seanslarla kalıcılığı artırılır.
Saç Dökülmesi Tedavisinde Kök Hücre
Saç dökülmesi genetik, hormonal veya stres kaynaklı olabilir.
Kök hücre tedavisinde saçlı deriye enjekte edilen hücreler, saç köklerini yeniden aktive eder.
Bu sayede saç dökülmesi durur, yeni saç büyümesi desteklenir ve mevcut saç telleri kalınlaşır.
PRP ve mezoterapiyle kombine edildiğinde sonuçlar daha hızlı alınır.
Jinekolojide Kök Hücre Uygulamaları
Kök hücreler, kadın sağlığında da yenileyici etki sağlar.
Vajinal bölgeye uygulandığında:
-
Doku elastikiyeti artar
-
Kuruluk azalır
-
Cinsel fonksiyon iyileşir
-
Estetik görünüm yenilenir
Ayrıca doğum sonrası deformasyonların onarımı ve menopoz sonrası rejuvenasyon için de tercih edilir.
Eklem ve Kas Onarımında Kök Hücre
Ortopedik uygulamalarda kök hücreler, hasarlı kıkırdak ve kas dokularını onarır.
Diz, kalça ve omuz gibi yük taşıyan eklemlerde hücreler bölgeye enjekte edilir, burada yeni doku oluşumu başlatılır.
Bu yöntem, cerrahi gerektirmeden hareket kabiliyetini artırır ve ağrıyı azaltır.
Anti-Aging Etkisi
Kök hücre tedavileri yaşlanmayı geciktirici etkiye sahiptir.
Hücresel yenilenme sağlandığında:
-
Enerji seviyesi yükselir
-
Uyku kalitesi artar
-
Ruh hali dengelenir
-
Bağışıklık sistemi güçlenir
-
Cilt, saç ve kas dokuları gençleşir
Bu nedenle kök hücre uygulamaları, biohacking ve fonksiyonel anti-aging protokollerinin en önemli bileşenlerinden biridir.
Tedavi Süreci ve Uygulama Aşamaları
-
Hazırlık:
Kişiden küçük bir doku veya kan örneği alınır.
Bu örnek, laboratuvar ortamında steril koşullarda kök hücre izolasyonuna tabi tutulur. -
Yoğunlaştırma:
Elde edilen hücreler özel filtreleme sistemlerinden geçirilir, saflaştırılır ve yoğunlaştırılır. -
Uygulama:
Elde edilen kök hücreler, hedef bölgeye (cilt, eklem, vajina, saç derisi vb.) mikro enjeksiyonlarla uygulanır.
İşlem genellikle 30–60 dakika sürer, anestezi gerekmez. -
Destek Protokolü:
Uygulama sonrası ozon, glutatyon ve vitamin serumlarıyla hücrelerin aktifleşmesi desteklenir.
Kök Hücre Tedavisinin Avantajları
-
Doğal ve güvenlidir (vücut kendi hücresini tanır).
-
Alerjik reaksiyon riski yoktur.
-
Hücresel düzeyde uzun süreli onarım sağlar.
-
Cerrahi müdahale gerektirmez.
-
Cilt, kas ve doku bütünlüğünü aynı anda yeniler.
-
Sonuçlar doğal görünür, zamanla artarak devam eder.
Bu özellikleri sayesinde kök hücre tedavileri, hem estetik hem de fonksiyonel gençleşme alanında devrim niteliğindedir.
Dr. Atasoy Kliniği’nin Yaklaşımı
Dr. Atasoy Kliniği’nde kök hücre tedavileri kişisel biyokimya, yaşam tarzı ve hormonal yapı dikkate alınarak planlanır.
Uygulama sonrası hastalara özel beslenme, serum desteği ve yaşam düzeni protokolleri hazırlanır.
Amaç yalnızca dış görünümü yenilemek değil, içsel gençleşmeyi başlatmaktır.
Dr. Atasoy’un bu konudaki yaklaşımı nettir:
“Kök hücre tedavisi, gençleşmeyi ciltte değil, hücrede başlatır.”